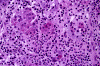
Com312-1-FR-HM.gif (134906 bytes)
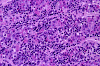
Com312-1-HM.gif (140067 bytes)

| A 28 year-old Woman with
Headache and Visual Disturbance. December, 2003, Case 312-1. Home Page |
Amir Ilyas, M.D.1, Kar-Ming Fung, M.D., Ph.D.2 Last update: December 30, 2003.
1Department of Neurology and 2Department of Pathology, University of Oklahoma Health Sciences Center, Oklahoma City, Oklahoma
Clinical information: The patient was a 28 year-old woman who presented with headache and visual disturbance. A CT scan performed in an outside institute revealed a pituitary mass that enlarged the sella and compressing the optic chiasma. The patien was afebrile and not pregnant. The serum prolactin level is mildly elevated to about two times normal value. There was no history of compromised immunity or significant problem in the paranasal sinus. A surgery was performed. The following photographs are taken from representative areas of the surgical sample.
Pathology of the case:
 |
 |
|
 |
|
|
| A. | B. | C. | D. | E. |
Panel A is an intraoperative cytologic preparation. Panel B and C are low- and high-magnification of intraoperative frozen section respectively. Panel D and E low- and high-magnification of formalin fixed paraffin embedded sections respectively.
Macroscopically, the specimen is composed of small fragments of soft pink tissue. A cytologic preparation (squash preparation) was performed (Panel A) and demonstrated three major types of cells. The larger cells with medium amount of amphophilic cytoplasm have nuclei with features of neuroendocrine cells characterized with round nuclei with fine "salt and pepper" chromatin. They are most consistent with anterior pituitary cells. It is not possible to comment on whether they are neoplastic or non-neoplastic on this cytologic preparation. Many small cells, mostly naked, with dark nuclei are also present. They are most consistent with lymphocytes. A small number of cells with features of polymorphonuclear leukocytes are also present.
Low-magnification (Panel B ) of the frozen sections shows anterior pituitary tissue infiltrated by lymphocytes with formation of lymphoid aggregates. On high-magnification (Panel C)the epithelial cells nests are composed of cells with amphophhilic or eosinophilic cytoplasm. These cells are the residual anterior pituitary cells. The presence of different cell types but not a monotonous cell type indicated that the lesional tissue is non-neoplastic anterior pituitary tissue. An inflammatory infiltration composed predominantly of lymphocytes and small number of polymorphonuclear leukocytes is present. It appears that some of the epithelial cell nests are infiltrated by inflammatory cells. Note that the cytologic features of these cells are much better preserved in the (Panel A). As a general rule in intro-operative consultation in surgical neuropathology, the cytologic preparation provides the cytologic details and the frozen sections provide the architectural (histologic) information.
Findings on the permenant sections are not that much different from the frozen sections. There is widespread lymphocytic infiltration in anterior pituitary tissue. Residual islands of anterior pituitary cells in form of pink clusters of cells at this magnification can be well recognized (Panel D). Residual anterior pituitary cells with amphophilic cytoplasm (chromophobes) and eosinophilic cytoplasm (acidophils) are present. There are also scant eosinophils. No cellular atypia is noted in either the inflammatory component or epithelial component (Panel D and E).
| DIAGNOSIS: Lymphocytic hypophysitis. |
Discussion: General Information Imaging Pathology and pathogenesis Differential diagnosis
General Information
Lymphocytic hypophysitis is a rare disorder. It was first described by Goudie and Pinkerton 1 in 1962. Lymphocytic hypophysitis has a definite female predilection of apporximately 8.5:1 2. It typically affects young women in peripartum period with a mean age of 34.5 years; post-menopausal women and men 3 are far less commonly affected.
Clinically and radiologicaly , lymphocytic hypophysitis can mimic a non-secretory
pitutary adenoma. Partial or complete loss of adenohypophysisal function is
common
4.
Diabetes insipidus is a rare manifestation but may also indicate involvement of
the infundibulum. A similar process known as infundibuloneurohypophysitis may
affect the neurohypophysitis and infundibulum only and manifests as diabetes
insipidus
5.
Headache, visual disturbances secondary to mass effects on the optic chiasma are
common. Amenorrhoea is often seen in women and loss of libido in men. Mild
prolactinemia has been reported in cases not associated with pregnant and breast
feeding. The prolactinemia may be resulted from compression of the infundibulum.
Alternatively, the inflammation may have altered the domine receptors and the
tonic inhibitory effect of dopamine on prolactin release. Pituitary apoplexy
associated with lymphocytic hypophysitis has also been described
6.
The outcome of lympmhocytic hypophysitis is variable. Some patients with only
partial loss of adenohypophysisal function may progress to panhypopituitarism
while others may recover. Surgery is often necessary for relieve of pressure and for
diagnostic purpose. Corticosteroids have been successful in some case in
decreasing the size and promoting hormonaal recovery by reducing the
inflammation in the gland
7.
Imaging studies typically disclose an enlarged pituitary mass often with suprasellar extension. It is not always possible to distinguish lymphocytic hypophysitis from a pituitary adenoma or hyperplasia. On CT and MRI, there is diffuse enlargement of the anterior pituitary gland without changes in internal characteristics of the gland or focal abnormality. Radiologic abnormalities in neurohypophysitis may suggest lymphocytic hypophysitis which is an inflammatory process rather than adenoma. These features include loss of hyperintense “bright spot” in normal neurohypophysis, thickening of the infundibulum, and enlargement of the neurohypophysitis 5, 8, 9.
Pathology and pathogenesis
The histopathology of lymphocytic hypophysitis is well illustrated in this case. In essence, there is a lymphoplasmacytic infiltrate in a background of adenohypophysial tissue. There is a variable number of neutrophils, eosinophils, and histiocytes. Lymphoid aggregates are common features. The infiltrating lymphocytes are polyclonal in nature and can be well demonstrated by immunohistochemistry. This is a useful feature that distinguish lymphocytic hypophysitis from neoplastic lymphoproliferative disorders. A variable degree of fibrosis and atrophy of the adenohypophysial tissue tissue can be seen. The residual adenohypophysial epithelial cells may exist as small islands and may show oncocytic changes.
Lymphocytic hypophysitis is believed to be of autoimmune in pathogenesis. It is also associated with other autoimmune considered as autoimmune diseases such as Hashimoto thyroiditis, adrenalitis, and less commonly atrophic gastritis and lymphocytic parathyroiditis 2, 10, 11. These antibodies were detected in patients with lyphocytic hypophysitis and other hypopituitarism, but not seen in patients with non-functioning pitutary macroadenoma. Several autoantibodies have been detected in the serum of patients with lymphocytic hypophysitis. These antibodies include anti-human growth hormone, anti-pituitary gland specific factor 1a and 2 (PGSP1a and PGSP2) 12, and anti-human pituitary membrane antigens of 43, 46, 68 kd in molecular weight 13.
Differential diagnosis
Differentiation from pituitary adenoma morphologically is usually not a diagnostic challenge. Adenomas are composed of monotonous cells with rich vasculature. The reticulin network is disrupted. Significant inflammation is uncommon. In contrast, lymphocytic hypophysitis have preserved reticulin network. More than one type of adenohypophysial epithelial cells are usually present.
Germinoma can occur in the same location and in similar age group. However, the large and bizzare cells should can be distinguished from adenohypophysial epithelial cells with ease. Immunohistochemistry can also help. Involvement of the antierior pituitary by a neoplastic hematopoietic process, particularly leukemic infiltration, lymphoma, and plasmacytoma can mimic lymphocytic hypophysitis. Immunohistochemistry will show a monoclonal population in the infiltrating hematopoietic cells.
Other inflammatory and infectious process such as tuberculosis, sarcoidosis, and giant cell granuloma can be distinguished by the presence of granulomatous cells.
Reference:
Goudie
RB, Pinkerton PH. Anterior
hypophysitis and Hashimoto's disease in a young woman.
J Pathol Bacteriol 1962;83:584-585.
Thodou
E, Asa SL, Kontogeorgos G, Kovacs K, Horvath E, Ezzat S. Clinical case
seminar: lymphocytic hypophysitis: clinicopathological findings. J
Clin Endocrinol Metab. 1995; 80:2302-11.
Lee
JH, Laws ER Jr, Guthrie BL, Dina TS, Nochomovitz LE. Lymphocytic
hypophysitis: occurence in two men. Neurosurgery
1994;34:159-162.
Asa SL, Bilbao JM, Kovacs K, Josse RG, Kreines K. Lymphocytic hypophysitis of pregnancy resulting in hypopituitarism: a distinct clinicopathologic entity. Ann Intern Med. 1981; 95:166-71.
Imura H, Nakao K, Shimatsu A, Ogawa Y, Sando T, Fujisawa I, Yamabe H. Lymphocytic infundibuloneurohypophysitis as a cause of central diabetes insipidus. N Engl J Med. 1993; 329:683-9.
Dan NG, Feiner RI, Houang MT, Turner JJ. Pituitary apoplexy in association with lymphocytic hypophysitis. J Clin Neurosci. 2002; 9:577-80.
Beressi N, Cohen R, Beressi JP, Dumas JL, Legrand M, Iba-Zizen MT, Modigliani E. Pseudotumoral lymphocytic hypophysitis. hypophysitis successfully treated by corticosteroids alone; first case report. Neurosurgery. 1994; 35: 505-8.
Levine SN, Benzel EC, Fowler MR, Shroyer JV 3rd, Mirfakhraee M. Lymphocytic adenohypophysitis: clinical, radiological, and magnetic resonance imaging characterization. Neurosurgery. 1988; 22:937-41.
Abe T, Matsumoto K, Sanno N, Osamura Y. Lymphocytic hypophysitis: case report. Neurosurgery. 1995; 36:1016-9.
Yamamoto M, Murakami Y, Nishiki M, Kato Y. A case of autoimmune hypophysitis associated with Graves' disease. Endocr J. 2002; 49: 583-7.
Nishiki M, Murakami Y, Koshimura K, Sohmiya M, Tanaka J, Yabe S, Kobayashi I, Kato Y. A case of autoimmune hypophysitis associated with asymptomatic primary biliary cirrhosis. Endocr J. 1998; 45: 697-700.
Tanaka
S, Tatsumi KI, Kimura M, Takano T, Murakami Y, Takao T, Hashimoto K, Kato Y,
Amino N. Detection of autoantibodies against the pituitary specific
proteins in the patients with lymphocytic hypophysitis. European Journal of Endocrinology 2002; 147: 767-775
Nishiki M, Murakami Y, Ozawa Y, Kato Y. Serum antibodies to human pituitary membrane antigens in patients with autoimmune lymphocytic hypophysitis and infundibuloneurohypophysitis. Clin Endocrinol. 2001; 54: 327-33.